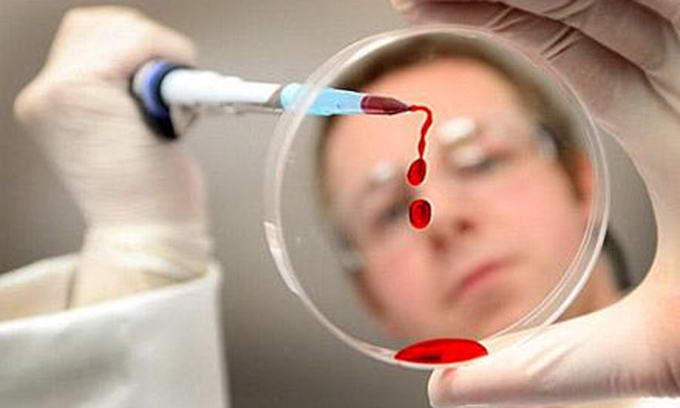

Вчені з Білорусі розробляють вакцину проти страху
В основі методики білоруських вчених лежить вплив на слизову оболонку носа ендотоксинів — фрагментів стінки кишкової палички, яка міститься в травному тракті кожної людини і важлива для активації імунної системи.
В основі методики білоруських вчених лежить вплив на слизову оболонку носа ендотоксинів — фрагментів стінки кишкової палички, яка міститься в травному тракті кожної людини і важлива для активації імунної системи. Під час експериментів над тваринами вчені помітили значні зміни в їх поведінці.
«Наприклад, пацюки та миші переставали ховатися в норах і відважно переміщувалися по відкритому просторі, що для них не характерно у звичайній ситуації», — розповів заступник директора з наукової роботи Інституту фізіології Національної академії наук професор Володимир Кульчицький. Подібна методика застосовується і до людини.
«Невелика аплікація на слизову оболонку носа перед спортивними змаганнями або іншими хвилюючими подіями допоможе знайти упевненість в своїх силах і налаштуватися на перемогу, — пояснив Володимир Кульчицький. — При правильному підході вона абсолютно безпечна для здоров'я і не повинна вважатися допінгом», — інформують argumenti.ru
За допомогою цього відкриття вчені сподіваються знайти нові шляхи боротьби з психічними захворюваннями та розладами.






